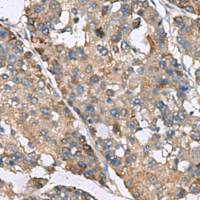
兔抗IP6K2多克隆抗体

万千商家帮你免费找货
0 人在求购买到急需产品
- 详细信息
- 技术资料
- 抗体名:
小鼠抗RPL10A单克隆抗体
- 抗体英文名:
Anti-RPL10A mouse monoclonal antibody
- 应用范围:
仅供科研使用
- 宿主:
Mouse
- 供应商:
上海酶联生物科技有限公司
- 库存:
111
- 抗原来源:
RPL10A
- 保质期:
1年
- 适应物种:
Human
- 标记物:
Unconjugate
- 克隆性:
单克隆
- 保存条件:
冷冻(-20℃)
- 形态:
液体
- 免疫原:
Fusion protein of human RPL10A
- 规格:
100ul
小鼠抗RPL10A单克隆抗体
英文名称: Anti-RPL10A mouse monoclonal antibody
别 名: ribosomal protein L10a; L10A; CSA19; NEDD6; Csa-19
相关类别: 一抗
上海酶联生物科技有限公司在保证质量同时,以价格优、到货快、服务周到、诚信交易为宗旨与理念,致力于各种生物试剂、抗体、细胞因子、实验耗材的销售推广及服务工作,凡购买我司抗体,全程为您提供技术支持与服务,酶联生物,您科研事业的鼎力支持者、佳拍档!
公司优势:
1.公司主营试剂盒、生化试剂、抗体、标准品等科研前沿产品。
2.我司产品针对性强,主要面向各大高校科研基地、科研机构以及研发性企业的客户。
3.公司拥有的专业背景,不仅能与国际接轨,还具备自身的研发实力。
4.我司以一批的专业技术人才,全程为您提供周到的技术服务和支持。
5. 公司提供的产品有任何质量问题,包退换。
6. 现货供应,供货周期短,能满足客户的急需,欢迎来电咨询。
酶联提醒
各位从事科研工作的小伙伴们,实验中所用到的试剂、配制试剂的液体,有时可能是实验成败的关键,因此大家在使用时一定要留意各种试剂的级别;原则上讲,纯度越高越,但是价格也就越高,所以要根据各自的需要选择合适的品质,避免不必要的浪费!
订购流程:
1、报价含普票、运费。
2、常用试剂备货充足,除对温度要求极其严格的产品当天可发货。
3、进口原装产品要3-6周的货期,详细情况请咨询客服。
4、订货时间为工作日每周一至周五16:00之前。
5、产品因运输途中包装破损请拒绝签收,做退回,我们将在24小时之内为您补发损坏产品。
6、如因单位财务制度原因,可申请先发货,报账后付款(此条款仅限科研所、医学院等信誉良客户)。
关注同酶联商铺产品:
英文名称: Anti-RPL10A mouse monoclonal antibody
别 名: ribosomal protein L10a; L10A; CSA19; NEDD6; Csa-19
相关类别: 一抗
上海酶联生物科技有限公司在保证质量同时,以价格优、到货快、服务周到、诚信交易为宗旨与理念,致力于各种生物试剂、抗体、细胞因子、实验耗材的销售推广及服务工作,凡购买我司抗体,全程为您提供技术支持与服务,酶联生物,您科研事业的鼎力支持者、佳拍档!
公司优势:
1.公司主营试剂盒、生化试剂、抗体、标准品等科研前沿产品。
2.我司产品针对性强,主要面向各大高校科研基地、科研机构以及研发性企业的客户。
3.公司拥有的专业背景,不仅能与国际接轨,还具备自身的研发实力。
4.我司以一批的专业技术人才,全程为您提供周到的技术服务和支持。
5. 公司提供的产品有任何质量问题,包退换。
6. 现货供应,供货周期短,能满足客户的急需,欢迎来电咨询。
酶联提醒
各位从事科研工作的小伙伴们,实验中所用到的试剂、配制试剂的液体,有时可能是实验成败的关键,因此大家在使用时一定要留意各种试剂的级别;原则上讲,纯度越高越,但是价格也就越高,所以要根据各自的需要选择合适的品质,避免不必要的浪费!
订购流程:
1、报价含普票、运费。
2、常用试剂备货充足,除对温度要求极其严格的产品当天可发货。
3、进口原装产品要3-6周的货期,详细情况请咨询客服。
4、订货时间为工作日每周一至周五16:00之前。
5、产品因运输途中包装破损请拒绝签收,做退回,我们将在24小时之内为您补发损坏产品。
6、如因单位财务制度原因,可申请先发货,报账后付款(此条款仅限科研所、医学院等信誉良客户)。
关注同酶联商铺产品:
风险提示:丁香通仅作为第三方平台,为商家信息发布提供平台空间。用户咨询产品时请注意保护个人信息及财产安全,合理判断,谨慎选购商品,商家和用户对交易行为负责。对于医疗器械类产品,请先查证核实企业经营资质和医疗器械产品注册证情况。
技术资料小鼠抗RPL10A单克隆抗体
¥2000